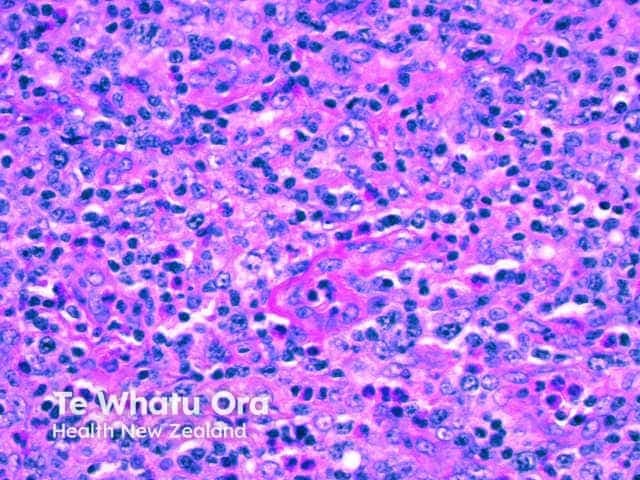

Main menu
Common skin conditions
NEWS
Join DermNet PRO
Read more
Quick links
Authors: Dr Flora Poon, Victorian Dermatology Registrar, St. Vincent’s Hospital, Melbourne, VIC, Australia; Dr Christopher Y Chew, Medical Resident, Monash Health, Melbourne, VIC, Australia; Dr Rubeta N Matin, Consultant Dermatologist, Oxford University Hospitals, Oxford, UK. DermNet Editor in Chief: Adjunct A/Prof. Amanda Oakley, Dermatologist, Hamilton, New Zealand. Copy edited by Gus Mitchell. March 2020.
Introduction Demographics Causes Clinical features Complications Diagnosis Differential diagnoses Treatment Outcome
Angioimmunoblastic T-cell lymphoma is a rare nodal peripheral T-cell lymphoma (PTCL) that results in systemic symptoms and profound immune deficiency [1]. It sometimes causes a rash.
Angioimmunoblastic T-cell lymphoma is characterised histologically by a polymorphous infiltrate primarily involving lymph nodes, a proliferation of high endothelial venules, and follicular dendritic cells [2].
Angioimmunoblastic T-cell lymphoma is rare.
Typically, angioimmunoblastic T-cell lymphoma affects older adults [4]. The median age of diagnosis is 62–65 years. Incidence is equal in men and women [4].
No risk factors have been identified for angioimmunoblastic T-cell lymphoma.
The cell of origin of angioimmunoblastic T-cell lymphoma is the follicular helper T-cell [4]. Malignant transformation has been associated with mutations in the epigenetic regulators (TET2, IDH2 and DNMT3A), the Ras homolog gene family member A (RHOA) and T-cell receptor pathway (CD28, FYN, PLCG1, CARD11, P13K elements, CTNNB1, and GTF2I) [4].
Angioimmunoblastic T-cell lymphoma is promoted by the overexpression of angiogenic mediators (factors that regulate the development of blood vessels), such as vascular endothelial growth factor (VEGF) and interleukin (IL)-8, and cytokines that are proinflammatory (IL6, IL18), immunosuppressive (IL10), or induce proliferation (IL21) [4,5].
Infectious diseases associated with angioimmunoblastic T-cell lymphoma include Epstein-Barr virus (EBV, the cause of infectious mononucleosis), human herpesvirus 6 (HHV-6) (the cause of roseola), HHV-8 (the cause of Kaposi sarcoma), human immunodeficiency virus (HIV), bacterial infections and fungal infections [4].
EBV establishes lifelong persistent infection in B cells. The immunodeficiency caused by angioimmunoblastic T-cell lymphoma reactivates EBV [4,6–8].
More than 70% of patients with angioimmunoblastic T-cell lymphoma present with constitutional symptoms. These include fevers, chills, night sweats, malaise, weight loss, arthralgias, and in 50%, a rash [11].
Lymphadenopathy and hepatosplenomegaly are typically present on examination. Pleural effusions, ascites, neurological signs, and gastrointestinal symptoms are less common [4].
Angioimmunoblastic T-cell lymphoma most often presents with a non-specific rash [11]. It can also result in papules, nodules, plaques, ulcers, petechiae, and, rarely, erythroderma [8,11,12].

Eroded papules and plaques in paraneoplastic pemphigus
Patients with angioimmunoblastic T-cell lymphoma are at increased risk of a secondary B-cell lymphoma, particularly diffuse large B-cell lymphoma (DLBCL), and less commonly, Hodgkin lymphoma, or plasmacytoma [13].
There are 30 documented cases of EBV-associated B-cell lymphomas in patients with angioimmunoblastic T-cell lymphoma (November 2019) [14–16].
EBV-induced diffuse large B-cell lymphoma can also present with cutaneous signs, including ulcerated papules, nodules, and abscesses [16].
Laboratory abnormalities include:
Peripheral blood leukocytosis with lymphocytosis is uncommon. Flow cytometry can be used to detect aberrant T-cells [17].
The diagnosis of angioimmunoblastic T-cell lymphoma is typically established by lymph node biopsy.
There are five angioimmunoblastic T-cell lymphoma histopathological patterns in the skin.

The immunophenotype of neoplastic cells typically corresponds to follicular T-helper cells (CD3+, CD4+, CD8−, CD10+, PD-1+, ICOS+, Bcl-6+, chemokine ligand CXCL13+) plus clusters of CD21+ follicular dendritic cells.
EBV positivity found on an immunohistochemistry stain is reportedly higher in more mature lesions and occasionally forms diffuse patterns [18].





The differential diagnosis of cutaneous angioimmunoblastic T-cell lymphoma depends on the morphology of the cutaneous rash, but can include:
Due to the rarity of angioimmunoblastic T-cell lymphoma, therapy is generally guided by prospective phase II studies [4].
Angioimmunoblastic T-cell lymphoma is typically aggressive with a median survival of fewer than 3 years, even with intensive treatment. Patients usually present with late stage III-IV disease, and survival rates have been quoted as being 33% 5 years and 29% at 7 years [18].
Circulating EBV DNA levels may be monitored; higher levels are associated with poorer prognosis. However, the presence of EBV in nodal tumours does not alter prognosis.
Secondary B-cell lymphomas have a typically poor prognosis. Eight out of 30 patients with EBV-associated B-cell lymphoma survived beyond 12 months [14–16].